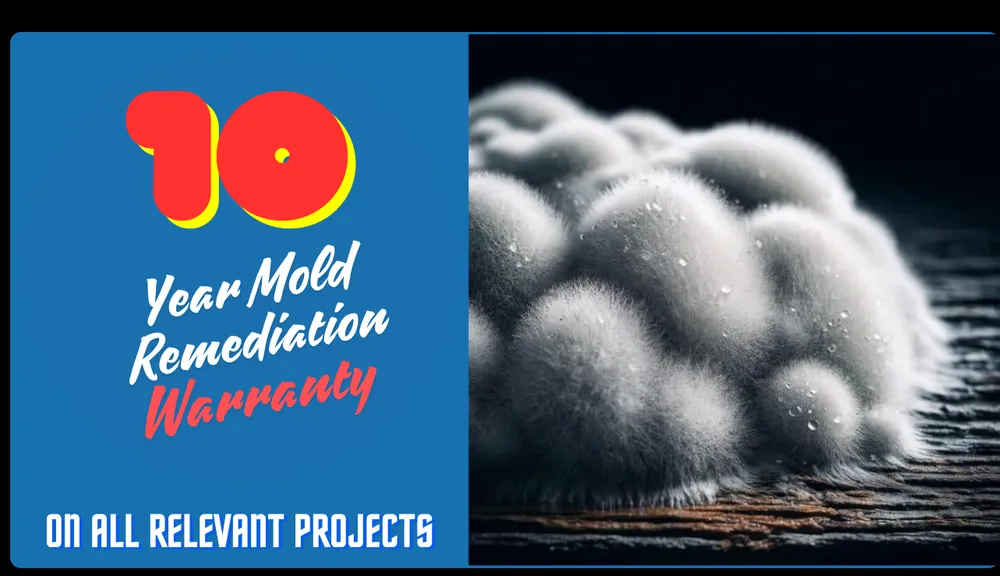
Slide of Envirosmart Solution

Envirosmart Solution | Insulation Installation & HVAC in Kent, WA 98032
1819 Central Ave S Ste 26, Kent, WA 98032
Main Services
- Insulation inspection
- HVAC system maintenance
- HVAC system repair
- Insulation replacement
- Air duct filter replacement
- HVAC installation or replacement
- Building energy audit
- Insulation installation
Meet the Team
Envirosmart Solution Inc. is a local, family-owned business in Kent, WA, founded in 2004. Our purpose is to provide the best service experience and build long-term relationships with our customers throughout the Puget Sound area. We are your neighbors, living and working right here in the community. Our team of licensed, insured, and trained technicians offers a one-stop shop for making your home safe, energy-efficient, and comfortable. We handle everything from attic and crawl space insulation, vapor barriers, and air duct cleaning to full HVAC installation, repair, and maintenance. We focus on your needs, not just the transaction, to be your trusted partner for all energy efficiency and indoor air quality solutions.
Questions and Answers
Why is my heat pump struggling in our Kent climate, and what can you do?
The wet, cool winters and seasonal temperature swings in our area can strain heat pump systems, leading to performance drops or failures. Our trained technicians specialize in diagnosing these local climate-related issues. We provide thorough inspections, repairs, and maintenance to ensure your system runs efficiently year-round. If a replacement is needed, we offer expert HVAC installation tailored to your home's specific needs and the demands of the Puget Sound weather.
How does air duct cleaning improve my home's air quality and efficiency?
Over time, dust, allergens, and debris accumulate in your ductwork, reducing your HVAC system's efficiency and circulating pollutants. Our service includes a comprehensive cleaning, sanitization, and filter replacement. This process helps your system run more smoothly, potentially lowering energy bills, and contributes to a healthier indoor environment by removing contaminants from the air you breathe daily.
What's involved in your insulation inspection for my attic or crawl space?
Our inspection is a detailed assessment of your current insulation's condition, coverage, and R-value. We check for gaps, moisture issues, pest damage, and compliance with local building standards. Based on our findings, we provide clear recommendations, which may include adding new insulation, removing old or damaged material, or installing radiant or vapor barriers. This service is designed to identify and fix the root causes of energy loss in your home.
Business Location & Hours
| Mon: | 8:00 AM - 6:00 PM |
| Tue: | 8:00 AM - 6:00 PM |
| Wed: | 8:00 AM - 6:00 PM |
| Thu: | 8:00 AM - 6:00 PM |
| Fri: | 8:00 AM - 6:00 PM |
| Sat: | 8:00 AM - 6:00 PM |
| Sun: | 10:00 AM - 6:00 PM |